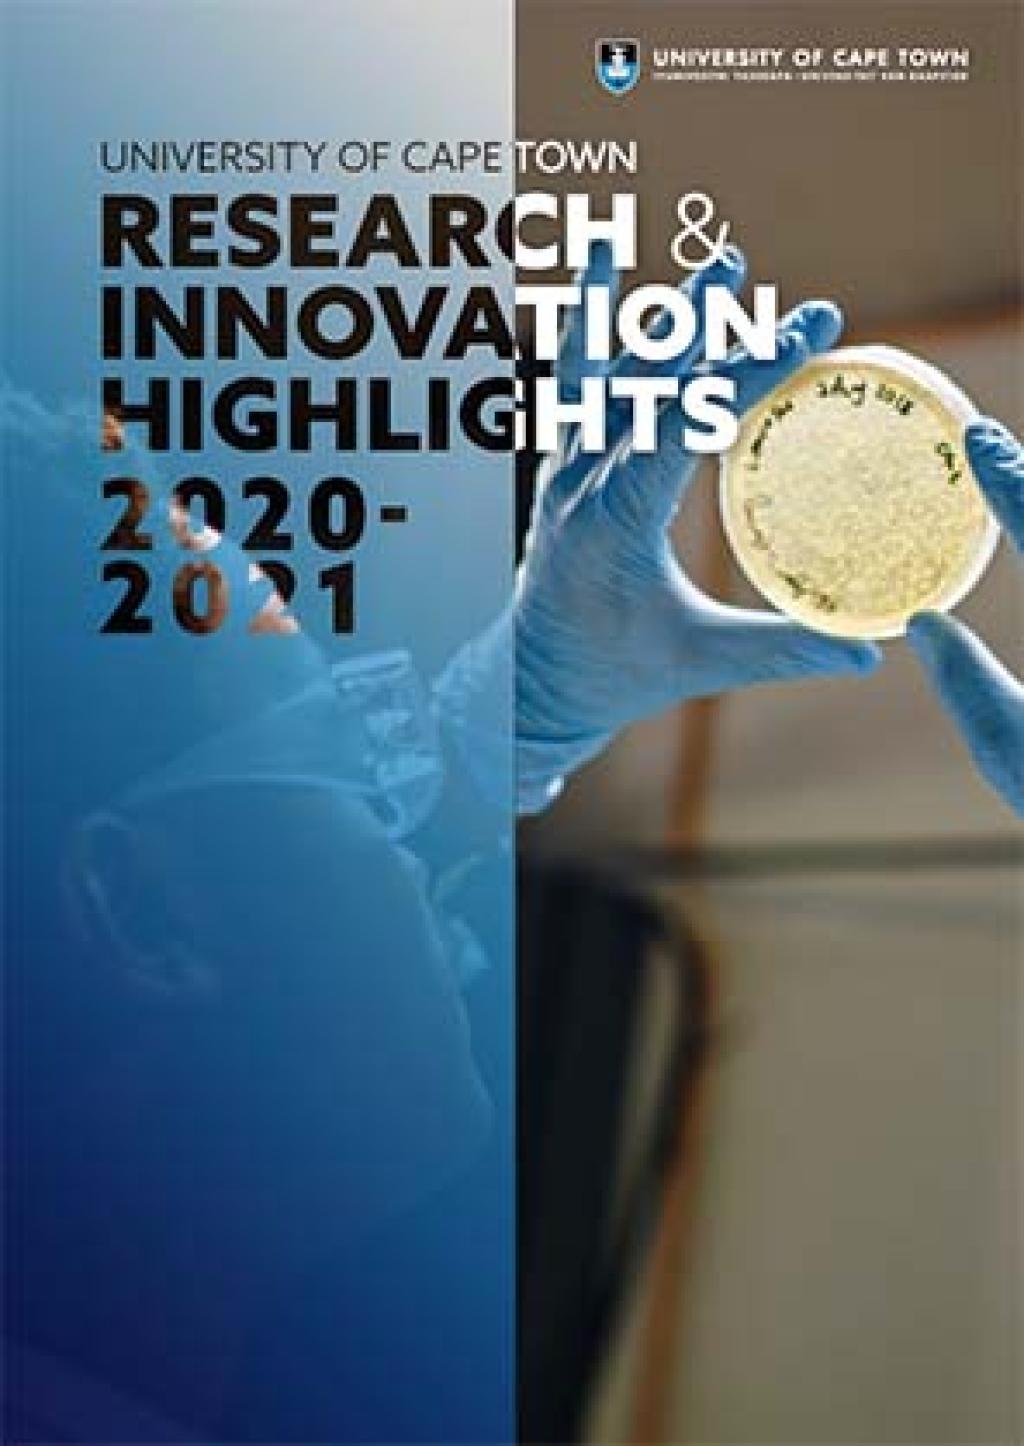
Research reports

These are the latest publications available about UCT research and innovation.
Sustainability and the SDGs

Sustainability and the SDGs Reports on SDG-focused research, innovation and knowledge translation happening at UCT.
eResearch reports
Archive of annual eResearch reports covering activities, challenges and opportunities at UCT.
Innovation reports
Archive of the Innovation annual reports profiling UCT inventions and inventors, and the activities of Research Contracts and Innovation.
Research & Innovation Highlights
Archive of the Research & Innovation Highlights reports, offering an overview of the remarkable work and achievements of UCT’s researchers for the year in review.
Research strategy: Vision 2030
Vision 2030 was developed to give expression to UCT’s massive transformative purpose.
Umthombo
The Umthombo magazine (2018-2019) featured stories of UCT’s ground-breaking research and researchers.